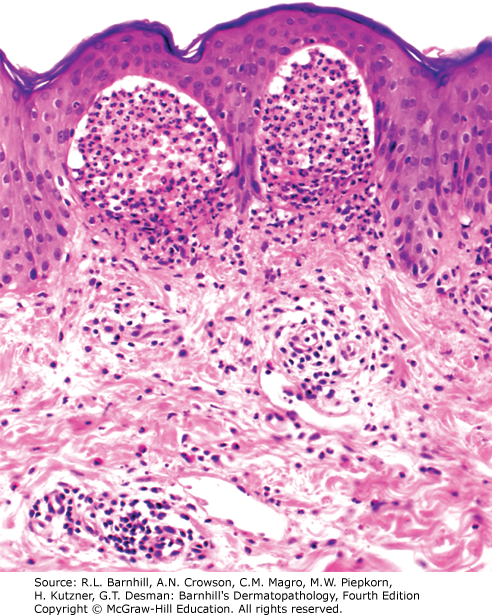

Dermatology Question of the Week: Deductive Dermpath

A 45-year-old male presents with the following rash.

Which of the following histologic images would be expected if you were to biopsy the rash?
A. 
B.
C. 
D. 
E. 
Rationale: The patient presents with well-demarcated pink-violaceous scaly plaques on the lower back and extensor surfaces of the upper extremities consistent with psoriasis.
Correct answer: E.
Epidermal acanthosis, elongation of the rete ridges, dilated vessels within the dermal papillae, and parakeratosis with neutrophils within the stratum corneum are all features seen in the image above and consistent with psoriasis.
Incorrect answers:
A. Shows significant spongiosis and acanthosis as well as infiltration of the vessel walls. This type of pattern would be observed in an eczematous process, not psoriasis.
B. Shows a neutrophilic infiltrate at the dermal papillae with subepidermal clefting consistent with dermatitis herpetiformis.
C. Shows significant edema and a predominantly neutrophilic dense infiltrate consistent with sweet syndrome.
D. Shows a dense band of lymphocytes at the dermoepidermal junction along with hypergranulosis consistent with lichen planus.
Additional reading at Barnhill's Dermatopathology Chapter 4: Psoriasiform Dermatitis

Create a Free MyAccess Profile
AccessMedicine Network is the place to keep up on new releases for the Access products, get short form didactic content, read up on practice impacting highlights, and watch video featuring authors of your favorite books in medicine. Create a MyAccess profile and follow our contributors to stay informed via email updates.